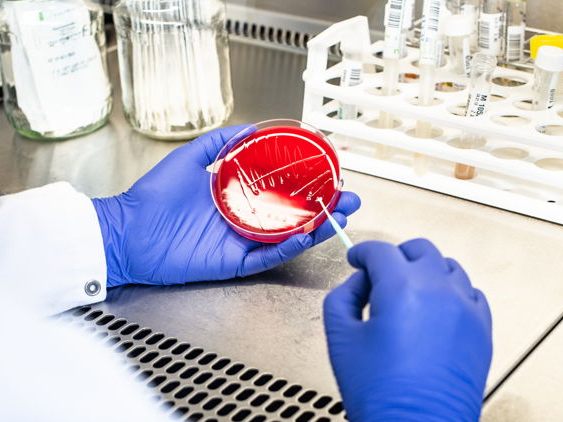

In Krimis sind es meistens die Pathologen, die nach der Untersuchung des Opfers den entscheidenden Hinweis zur Ergreifung eines Täters geben. Im wirklichen Leben hat die Arbeit der Pathologie jedoch gar nichts mit Kriminalfällen zu tun. Dafür ist die Gerichtsmedizin zuständig. „Wir Pathologen beschäftigen uns hauptsächlich mit der Erkennung und Diagnostik von Erkrankung von lebenden Patienten“, erklärt Primar Felix Offner, Leiter des Instituts für Pathologie im LKH Feldkirch. Die Proben von rund 100.000 Patienten gehen jährlich durch die Hände des Instituts-Personals. Die Ergebnisse aus den Untersuchungen sind häufig die Basis für die erforderlichen Therapien.
Schnelle Ergebnisse
Beim Med Konkret am Dienstag, 29. April 2025, erläutern Primar Offner und die Mikrobiologin Dr. Susanne Neumayer, was die Pathologie bei chronischen Erkrankungen leisten kann, und wie wichtig sie ist, um solche Erkrankungen zu verstehen und gezielt behandeln zu können. Außerdem liefern die Fachärzte einen Einblick in die verfügbaren modernen Diagnosetechniken. Die Online-Vorträge beginnen um 18 Uhr, die Teilnahme ist frei.
Die Pathologie ist Krankheitslehre und Krankheitsforschung. „Es geht vor allem aber auch um die Gesunderhaltung der Menschen“, sagt Felix Offner. Die Möglichkeiten innerhalb dieses medizinischen Bereichs haben sich in den vergangenen Jahren und Jahrzehnten enorm weiterentwickelt. Als Beispiel nennt Offner den sogenannten Multiplex-PCR-Test. „Damit lassen sich alle für eine Erkrankung relevanten Erreger in einem Durchgang herausfiltern“, verdeutlicht er den Fortschritt. Das bringt eine große Zeitersparnis. In der Vorsorge gynäkologischer Tumore kommt etwa statt dem bekannten PAP-Abstrich immer häufiger der Test auf Humane Papillomaviren (HPV) zum Einsatz. Der Multiplex-PCR-Test legt binnen kürzester Zeit offen, welche HP-Viren, von denen es über 100 gibt, vorliegen. „Der Test reagiert viel genauer und ist der Zytologie daher klar überlegen“, weiß der Experte. Fällt der Test negativ aus, ist das Risiko für einen Gebärmutterhalskrebs sehr gering, sodass die Untersuchungsintervalle reduziert werden können.
Umfangreicher Versorgungsauftrag
Das Institut für Pathologie im LKH Feldkirch hat einen umfangreichen Versorgungsauftrag. Die insgesamt 80 Mitarbeitenden führen zytologische, histologische, immunhistologische, molekularbiologische, medizinisch-mikrobiologische, infektionsserologische und krankenhaushygienische Untersuchungen sowie klinische Autopsien durch. Die technische Ausstattung dafür reicht von der Mikroskopie über die Immunologie und Biochemie bis zur Proteomanalyse und Molekulargenetik.
Online dabei sein? So einfach funktioniert‘s
- Auf den Teilnahme-Link klicken: Dieser Link wird für jede Webinar-Veranstaltung neu generiert und Ihnen hier auf VOL.AT rechtzeitig zur Verfügung gestellt. Der Link leitet Sie zur Webseite zoom.us.
- Auf zoom.us registrieren: Die Registrierung ist notwendig, um Fragen stellen zu können.
- Hilfsdienst installieren: Zoom bittet Sie einen Hilfsdienst zu installieren. Führen Sie die Installation bitte aus, um Zoom am PC zu starten.
- Fragen stellen: In der unteren Leiste finden Sie die Option F&A (Fragen und Antworten). Hier können Sie Fragen (auch anonym) eingeben. Beantwortet werden diese im Anschluss an den Vortrag.
Med Konkret
Pathologie: Schlüssel zur Diagnose
Referenten: Primar Felix Offner, Mikrobiologin Dr. Susanne Neumayer, LKH Feldkirch
Termin: Dienstag, 29. April 2025, ab 18 Uhr online
Die Teilnahme ist frei
Du hast einen Hinweis für uns? Oder einen Insider-Tipp, was bei dir in der Gegend gerade passiert? Dann melde dich bei uns, damit wir darüber berichten können.
Wir gehen allen Hinweisen nach, die wir erhalten. Und damit wir schon einen Vorgeschmack und einen guten Überblick bekommen, freuen wir uns über Fotos, Videos oder Texte. Einfach das Formular unten ausfüllen und schon landet dein Tipp bei uns in der Redaktion.
Alternativ kannst du uns direkt über WhatsApp kontaktieren: Zum WhatsApp Chat
Herzlichen Dank für deine Zusendung.